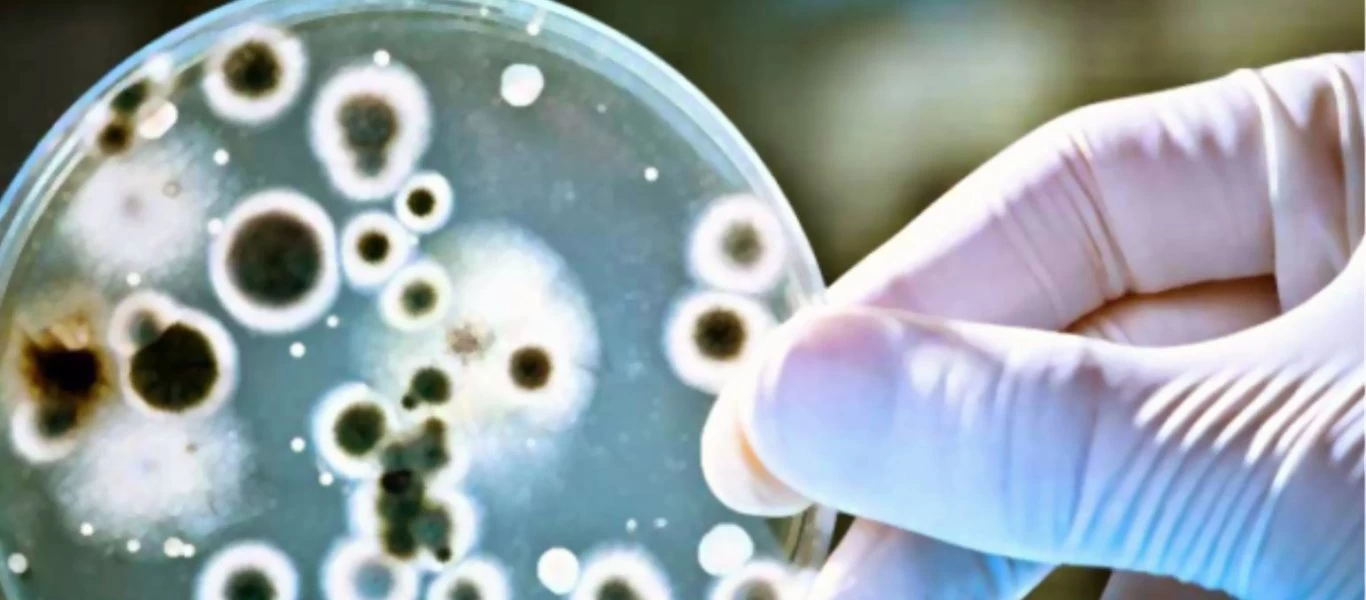
Ο serial killer μύκητας που έχει εξαφανίσει 90 είδη του ζωικού βασιλείου - Σκοτώνει περισσότερο από ότι ο άνθρωπος

Περιβάλλον
-

Κακοκαιρία: Πάνω από 8.500 κεραυνοί τη Δευτέρα - Πότε θα υπάρξει νέα επιδείνωση
Η κακοκαιρία τείνει προς εκτόνωση, καθώς από το πρωί της Τρίτης αναμένεται ηλιοφάνεια. Νέα επιδείνωση του καιρού από την Πέμπτη και την Παρασκευή.Προς εκτόνωση τείνουν τα καιρικά φαινόμενα, τα οποία έ...
Read More » -

Καιρός: Ισχυρές βροχές και καταιγίδες σήμερα - Σε κλοιό κακοκαιρίας η χώρα
Ο καιρός σήμερα σύμφωνα με την πρόγνωση της Εθνικής Μετεωρολογικής Υπηρεσίας (ΕΜΥ): Νεφώσεις με βροχές και σποραδικές καταιγίδες. Τα φαινόμενα στα δυτικά, πρόσκαιρα μέχρι το μεσημέρι στην Αττική και τ...
Read More » -

Κρήτη: Ψαράς αλίευσε με δόλωμα μια σουπιά... ροφό 7,5 κιλών! (βίντεο)
Με δόλωμα μια σουπιά, ο ροφός των 7,5 κιλών της φωτογραφίας «τσίμπησε» την 1η Νοεμβρίου, το αγκίστρι του ερασιτέχνη ψαρά Νικήτα Πατεράκη στην Κρήτη.Το ψάρι πιάστηκε στα νερά του Νότιου Κρητικού Πελάγο...
Read More » -

Γιατί δε νιώθουμε την ατμοσφαιρική πίεση; - Η επιστήμη απαντά
Η ατμόσφαιρα της Γης έχει αποδειχτεί επιστημονικά πως ασκεί σε όλους μας πίεση σε επίπεδο θάλασσας, η οποία ισοδυναμεί με περίπου 10 τόνους βάρους ανά τετραγωνικό μέτρο. Πιο απλά λοιπόν, αυτό σημαίνει...
Read More » -

Μαλαισία: Ξαφνιασμένοι από την αποκάλυψη πως μακάκοι σκοτώνουν και τρώνε αρουραίους ο επιστήμονες
Ξαφνιασμένοι με την αποκάλυψη πως οι μακάκοι κυνηγούν και τρώνε αρουραίους στη Μαλαισία, δήλωσαν οι επιστήμονες.Οι επιστήμονες ανακάλυψαν πως οι πίθηκοι σκοτώνουν και τρώνε τακτικά αρουραίους σε φυτεί...
Read More » -
Ο serial killer μύκητας που έχει εξαφανίσει 90 είδη του ζωικού βασιλείου - Σκοτώνει περισσότερο από ότι ο άνθρωπος
Εξελίσσεται στον μεγαλύτερο κίνδυνο για την πανίδα, ιδιαίτερα στα αμφίβια είδη. Τα τελευταία 50 χρόνια έχει σκοτώσει και εξαφανίσει 90 είδη, με τους επιστήμονες να σηκώνουν τα χέρια ψηλά στην αντιμετώ...
Read More » -

Κλιματική αλλαγή: Μέχρι και δύο μέτρα ενδέχεται να ανέβει η στάθμη της θάλασσας στη Μεσόγειο
Από μισό έως και τα δύο μέτρα αναμένεται να φθάσει, σε πολλές περιοχές της Μεσογείου, η άνοδος της στάθμης της θάλασσας, εξαιτίας της κλιματικής αλλαγής, μέχρι το τέλος του αιώνα.Αυτό έκανε γνωστό ο Α...
Read More » -

Θερμός και με υψηλές θερμοκρασίες αναμένεται να είναι ο φετινός χειμώνας (βίντεο)
Θερμός αναμένεται να είναι ο φετινός χειμώνας, τουλάχιστον το πρώτο μισό του, σύμφωνα με έρευνα του αμερικάνικου Accu Weather.Τα στοιχεία που δημοσιεύτηκαν στην ετήσια έκθεσή του για τον φετινό χειμών...
Read More » -

Δύτες εντόπισαν τα δόντια του μεγαλύτερου προϊστορικού καρχαρία μέσα σε υποβρύχιο σπήλαιο (βίντεο)
Ο μεγαλύτερος καρχαρίας που κολύμπησε ποτέ στους ωκεανούς του πλανήτη εξαφανίστηκε πριν από 1,5 εκατομμύρια χρόνια. Το μέγεθός του κυμαινόταν από 18 έως 20 μέτρα και το βάρος του συχνά έφτανε τους 100...
Read More » -

Αυτές είναι οι 9 περιοχές της Αττικής που κινδυνεύουν περισσότερο από τις πλημμύρες
Εννέα είναι οι περιοχές της Αττικής που κινδυνεύουν περισσότερο από μια καταστροφική πλημμύρα, σύμφωνα με το σχέδιο δράσεων πολιτικής προστασίας για την αντιμετώπιση κινδύνων από την εκδήλωση πλημμυρι...
Read More »
